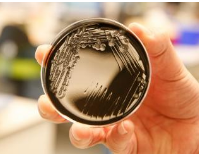

Bron van grootschalige legionellabesmetting in België lijkt gevonden
Het Belgische Agentschap Zorg & Gezondheid (AZG) heeft waarschijnlijk de bron van de grootschalige legionellabesmetting gevonden. De koeltoren van een bedrijf in de Gentse haven lijkt de boosdoener te zijn. De uitbraak rond het Oost-Vlaamse Evergem bij Gent begon eind april. Het totale aantal patiënten staat op 32, twee slachtoffers zijn overleden.
Legionella is een gevaarlijke bacterie die in drinkwatersystemen kan voorkomen, maar ook natte koeltorens kunnen een bron van besmetting zijn. Dat is een installatie die gebruikt wordt voor de afkoeling van een gebouw of een industrieel proces. De koeltoren vernevelt water, dat zich als een lichte mist verspreidt. Via de waternevel kunnen legionellabacteriën eenvoudig terechtkomen in de lucht die mensen inademen. Het AZG heeft bij zeventien bedrijven in de Gentse haven een watermonster uit de koeltorens gehaald en ontdekte een genetische overeenkomst tussen de legionellakiemen die bij vijf patiënten zijn vastgesteld en het monster uit een van die torens.(NU)…[+]





